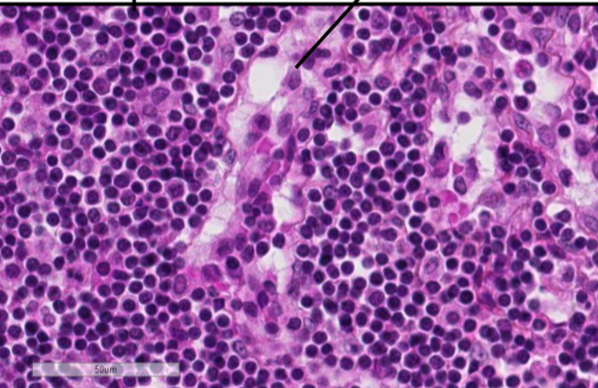

décrit ce qu’il y a sur cette lame

on voit un artère musculeuse (on le sait parceque la media est épaisse)
intima en haut constituée d’un endothélium avec une mince couche sous-endothéliale
Limitante elastique interne (sépare intima de la media)
Media = cellules musculaires lisses + fibres élastiques isolées
Limitante elastique externe (sépare la media de l’adventice)
Adventice qui est composée de fibre de collagène, vasovasorum, tissus adipeux et nerfs
décrit ce qu’il y a sur cette lame

veine (on le sait parce que la media est mince et la limitante elastique est peu visible) aussi al lumière est grande et irrégulière comparé aux artères
grande flèche= adventice
petite flèche= media
en dessous=intima
indique on est dans quelle lame et les structues

Lame de l’oesophage HES on observe les capillaires
de gauche à droite:
- péricytes
- cellule endothéliale sur une memb basale peu visible
- capillaires encore
- collagène associé au capillaire

combien de globule rouge de large passe dans un capillaire
1-2
dans un capillaire, on retrouve quoi comme couche ?
- adventice
- intima
- media
Juste l’intima (endothelium avec une membrane basale pas vrm visible, un péricyte et du collagène)
décrit ce quon voit ici

veinule (pas besoin de savoir la grosseur)
on le sait parce que media presque abscente
flèche de haut en bas:
- intima
- media
- adventice
On est dans quelle partie du ganglion lymphatique (cortex ou medulla?) et identifie les fleches

on est dnas le cortex (on peut voir la fin du ganglion)
Fleches de haut en bas:
- manteau (il est plus foncé)
- centre germinal (plus clair)
- sinus sous-capsulaire
- capsule conjonctive
Qu’est ce qui différencie le cortex de la medulla dans le ganglion lymphatique en hES
médulla est plus au centre, cortex sur le coté

ou on retrouve les lymphocytes T dans les ganglions lymphatiques
autour du follicule lymphoide du cortex
le manteau et le centre germinatif forment le …
les cell plus pales au niveau du centre germinal et du manteau reprensente des …
follicule lymphoide
lymphocytes B
quelle lame, donne les 3 couches

Lame de peau acrale de l’orteil (beaucoup de keratine)
de haut en bas
- hypoderme
- derme
- epiderme
ON retrouve des lymphocytes B … dans le manteau et des lymphocytes B … dans le centre germinatif
inactivé
activé
ON est dans quelle lame, quelle partie, nomme les fleches

lame de ganglion lymphatique au niveau de la medulla
- sinus medullaire (canal ou la lymphe circule)
- cordon medullaire
au niveau de la lame de ganglion lymphatique, niveau medulla, nomme les deux cellules qu’on voit
lymphocytes (petites cell foncées)
celle qui est pointée= cellule réticulé (elles soutiennent le canal)
Lame, les keratinocytes migrent de ou vers ou, différencie les couches

lame de peau acral de l’orteil, on observe l’épiderme
migrent de facon ascendante (vers la surface de la peau)
couche basale: membrane basale avec des cellules souches qui font de la division mitotique, on y retrouve aussi les melanocytes
couche épineuse: desmosomes ++
couche granuleuse: granules de keratohyaline dans cytoplasme
couche cornée : squames de keratine aplatie, pas de noyau ni de cytoplasme

Lame de peau acrale de l’orteil, on observe le derme (on voit a cause du collagène)
de haut en bas:
- nerf
- VS
- fibre de collagène (fibroblaste)
- papille dermique
- crête épidermique
Identifie les structure et la lame

lame de peau acrale de l’orteil HES, au niveau de l’hypoderme (on voit qu’il y a essentiellement des cell adieuses)
On y retrouve les glandes sudoripares
sécrétrices : cellules plus pales et plus grosses
excrétrices : cellules plus foncées et plus petites
Tissus adipeux en blanc (on enlève les lipides dans la prep)
Fibres de collagène en Orange (safran)
VS
quelle est cette lame et identifie le carré et la fleche

lame de cuir chevelu en HES
on voit dans le carré la couche corné de l’épiderme avec l’épiderme et le derme (en orangé)
la flèche montre les annexes cutanés

On voit ici la lame de cuir chevelu en HES encore mais zoom sur les annexes cutanés
l’unité pilosébasée se trouve dans le derme et comprend:
- glande sébacée
- muscle lisse erecteur du poil
- follicule pileux (qui ressemble a un tube)
- le poil ou cheveux fait de keratine


